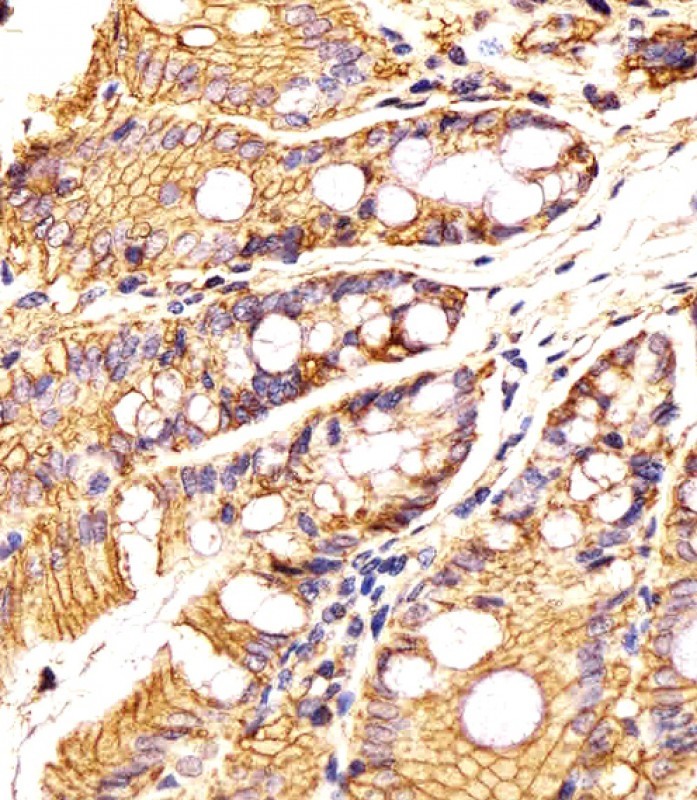

-
分类: 科研抗体货号: P32958别名: Cryptochrome-2, CRY2, KIAA0658应用: WB,IHC反应种属: Human, Mouse
-
分类: 科研抗体货号: P32939别名: GTPase ERas, E-Ras, Embryonic stem cell-expressed Ras, Eras应用: WB,FCM反应种属: Mouse
-
分类: 科研抗体货号: P32957别名: Ubiquitin carboxyl-terminal hydrolase 17-like protein 24, Deubiquitinating enzyme 17, Ubiquitin thioesterase 17, Ubiquitin-specific-processing protease 17, USP17L24应用: WB,FCM反应种属: Human
-
分类: 科研抗体货号: P32938别名: FUN14 domain-containing protein 1, fundc1应用: WB反应种属: zebrafish
-
分类: 科研抗体货号: P32956别名: Protein DGCR14, DiGeorge syndrome critical region 13, DiGeorge syndrome critical region 14, DiGeorge syndrome protein H, DGS-H, Protein ES2, DGCR14, DGCR13, DGSH, DGSI, ES2应用: WB反应种属: Human, Mouse, Rat
-
分类: 科研抗体货号: P32966别名: Conserved oligomeric Golgi complex subunit 1, COG complex subunit 1, Component of oligomeric Golgi complex 1, COG1, KIAA1381, LDLB应用: WB反应种属: Human, Mouse, Rat
-
分类: 科研抗体货号: P32955别名: Cyclin-dependent kinase 8, Cell division protein kinase 8, Mediator complex subunit CDK8, Mediator of RNA polymerase II transcription subunit CDK8, Cdk8应用: WB反应种属: Human, Mouse
-
分类: 科研抗体货号: P32965别名: Serine/threonine-protein phosphatase 2A 55 kDa regulatory subunit B gamma isoform, IMYPNO1, PP2A subunit B isoform B55-gamma, PP2A subunit B isoform PR55-gamma, PP2A subunit B isoform R2-gamma, PP2A subunit B isoform gamma, PPP2R2C应用: WB反应种属: Human, Mouse, Rat
-
分类: 科研抗体货号: P32953别名: Epithelial cell adhesion molecule, Ep-CAM, Epithelial glycoprotein 314, EGP314, mEGP314, Protein 289A, Tumor-associated calcium signal transducer 1, CD326, Epcam, Tacstd1应用: WB,IHC,FCM反应种属: Human, Mouse, Rat
-
分类: 科研抗体货号: P32963别名: E3 ubiquitin-protein ligase MYLIP-B, 632-, Myosin regulatory light chain-interacting protein B, MIR-B, mylipb {ECO:0000312|ZFIN:ZDB-GENE-061027-67}应用: WB反应种属: zebrafish

鄂公网安备42018502007531号
鄂公网安备42018502007531号

